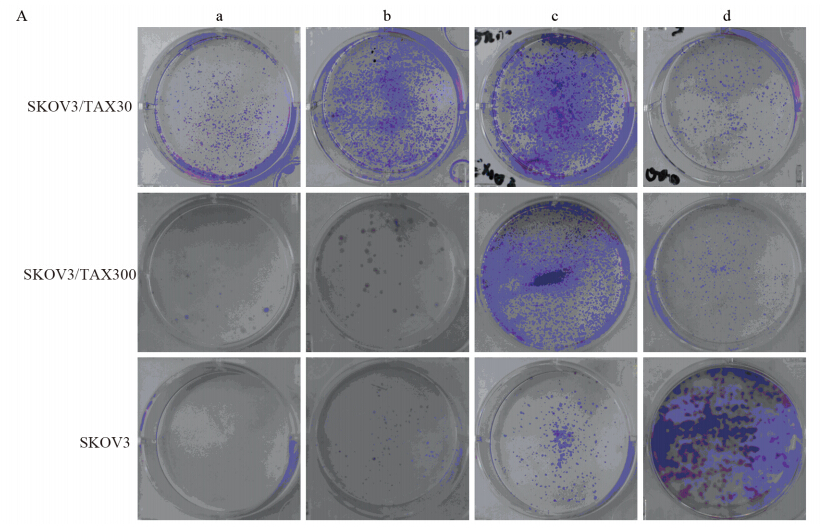

文章信息
- 樊蓓,李红霞,吴玉梅,赵群,邓小虹. 2015
- FAN Bei,LI Hongxia,WU Yumei,ZHAO Qun,DENG Xiaohong. 2015
- 紫杉醇诱导的卵巢癌耐药细胞株的生物学特性及其保存
- Biological Characteristics of Paclitaxel-resistance Ovarian Cancer Cell Lines and Cryopreservation Methods
- 肿瘤防治研究, 2015, 42(04): 334-339
- Cancer Research on Prevention and Treatment, 2015, 42(04): 334-339
- http://www.zlfzyj.com/CN/10.3971/j.issn.1000-8578.2015.04.004
-
文章历史
- 收稿日期:2014-08-17
- 修回日期:2014-11-11
2. 100038 北京,首都医科大学附属北京世纪坛医院妇产科
2.Department of Gynecology and Obstetrics,Beijing Shijitan Hospital, Capital Medical University, Beijing100038, China
卵巢癌病死率居妇科肿瘤首位,除了确诊时期晚以外,复发和化疗耐药是患者预后不良的主要原因[1, 2]。如何预测和克服耐药成为提高卵巢癌治愈率的关键因素。建立体外耐药模型是研究耐药机制的有效手段,但国内卵巢癌耐药细胞体外模型尚不多,尤其缺乏稳定的耐药细胞株。本研究应用大剂量冲击诱导法和小剂量浓度递增诱导法,建立紫杉醇诱导的卵巢癌耐药细胞株,探索耐药细胞的生物学特性及长期保存条件,以建立稳定的体外实验模型。1 材料和方法1.1 细胞株与细胞培养
人浆液性卵巢癌SKOV3细胞(北京世纪坛医院妇产科实验室),培养液为RPMI1640 (含10%进口胎牛血清、青霉素100 u/ml、链霉素100μg/ml),置于37℃、5%CO2培养箱中培养,0.25%胰蛋白酶消化传代。1.2 药品与试剂
紫杉醇(paclitaxel,6 mg/ml)购自海南制药公司;RPMI1640培养液、TRIzol试剂及引物均购自美国Invitrogen公司;胎牛血清(FCS)购自美国Hyclone公司;四甲基偶氮唑盐(MTT)购自美国Sigma公司;结晶紫购自北京鼎国生物公司;反转录系统购自美国Promega公司;Power SYBR Green PCR Master mix购自美国Applied Biosystems公司。1.3 耐药细胞株的建立1.3.1 大剂量冲击诱导方法
为使培养体系中药物的终浓度与体内有效血浆浓度接近,按如下公式计算: 用药浓度µg/ml=[(60 ×D)/5 000] × 2×103,式中“60”为平均成人体重(kg),“D”为临床用药剂量mg/(kg·d),“5 000”为平均成人血量,“2”为除以血细胞压积50%,“103”为将mg换算成µg。临床上卵巢癌患者紫杉醇+铂类常规月化疗方案的紫杉醇用药剂量为175 mg/m2,首先将体表面积的用药剂量换算为本公式中按公斤体重计算的用药剂量D,以临床中大剂量冲击疗法常用剂量的3倍为标准,计算本实验的细胞用药浓度为300 µg/ml[3]。300 µg/ml紫杉醇冲击对数期生长的SKOV3细胞2 h后,换无药培养液,待细胞恢复生长至对数期,消化传代再次冲击[3, 4]。1.3.2 小剂量浓度递增诱导方法
SKOV3细胞在37℃、5%CO2的条件下常规培养,至对数期生长期细胞密度约80%时,加入紫杉醇10 nM,培养24 h,改用无药培养液,细胞恢复生长至对数生长期时,同样浓度药物反复诱导,待细胞能耐受该药物浓度,基本无死亡时,递增提高药物浓度至20 nM重复诱导,最终紫杉醇的药物浓度递增为30 nM。耐药细胞在含紫杉醇30 nM培养液中传代培养。1.4 紫杉醇耐药细胞生物学特性的研究1.4.1 MTT法测定耐药指数(resistant index,RI)
取对数生长期的SKOV3敏感细胞和SKOV3耐药细胞,胰酶消化,调整悬液浓度为1×104/ml,以每孔200 µl接种于96孔板,37℃、5%CO2培养过夜,弃培养液。按10倍浓度梯度(紫杉醇100、10、1、0.1、0.01、0.001、0 µg/ml)加入200 µl含紫杉醇培养液,每组设5个复孔。另设只加RPMI1640培养液的调零孔。72 h后弃培养液,每孔加180 µl新鲜培养液,MTT(5 mg/ml)20 µl,培养4 h,吸弃培养液,每孔加二甲基亚砜150 µl,用自动酶标仪测570 nm波长各孔吸光度OD值。计算细胞存活率。细胞存活率=实验孔OD值/对照孔OD值×100%,以浓度-存活曲线作回归方程,求出半数致死量(IC50),耐药细胞株的IC50与敏感株的比值为耐药指数RI。1.4.2 平板克隆形成实验
SKOV3耐药细胞与SKOV3敏感细胞分别接种于6孔板中,按接种细胞数分为4组,各组细胞数分别为5×104个/孔(a组)、1×104个/孔(b组)、5×103个/孔(c组)、1×103个/孔(d组),每组设3个平行孔。24 h后,a组中加入500 nM紫杉醇,b组中加入50 nM紫杉醇,c组中加入5 nM紫杉醇,d组中加入0 nM紫杉醇,培养24 h,更换为正常无药培养液。10天后,以0.5%结晶紫(用甲醇配制)染色30 min。以每团细胞数大于50个作为一个克隆进行克隆计数。1.4.3 细胞生长曲线的检测(7天法)
对数期生长的细胞经消化、离心、调整细胞浓度后接种于24孔培养板,5×103细胞/孔。连续7天,每天取3孔计数,取其均值,绘制细胞生长曲线,细胞数为纵坐标,测量天数为横坐标。Patterson公式计算群体倍增时间(Td):Td=tlg2/lg(Nt/N0)。Td:倍增时间,t:培养时间(h),N0:接种时的细胞数,Nt:培养t小时后的细胞数。1.5 Real-time RT-PCR检测耐药相关基因MDR1、BCL2L1、LRP、PRKCA的表达
取对数生长期细胞,TRIzol试剂提取细胞总RNA,反转录试剂盒合成cDNA,SYBY Green方法进行实时荧光定量PCR实验。引物设计由I nvitr ogen公司合成,见表 1。PCR反应体系:cDNA 1 µl,2×SYBR Green PCR Master mix 12 µl,引物F/R(上下游引物的终浓度各为15 pmol/µl)各0.3 µl,DEPC水11.4 µl,共25 µl。PCR循环设置:50℃ 2 min → 95℃10 min → (95℃ 15 s → 60℃ 1 min)× 40个循环(生成扩增曲线)→95℃ 15s → 60℃ 15 s→95℃ 15 s(生成溶解曲线)。SDS2.2软件分析处理数据,管家基因校正目的基因的表达,得到相对定量结果。
![]() |
耐药细胞SKOV3/TAX30分别冻存于含0、10、30 nmol/L紫杉醇药物的冻存液里。于冻存后1、3、6月分别复苏细胞,观察复苏情况,MTT法检测IC50。1.7 统计学方法
对有关数据采用SPSS13.0软件进行独立样本t检验(independent sample t-test)、单因素方差分析(One way ANOVA),P<0.05为差异有统计学意义。 2 结果 2.1 耐药细胞的建立
SKOV3经300 μg/ml大剂量的紫杉醇作用2 h后,大部分细胞死亡漂浮,剩余细胞肿胀,伸出树枝状突起呈蜘蛛状,胞质见空泡形成、颗粒增多。少量存活的细胞克隆生长,恢复生长至对数期消化传代,再进行下一次冲击;SKOV3经10~30 nmol/L小剂量的紫杉醇作用24 h,约50%的细胞死亡,细胞体积增大,形态不规则,胞质内颗粒增多,贴壁性变弱,给药24~72 h内最明显,96~120 h后逐渐恢复原状。经两种诱导方法获得的耐药细胞系,分别命名为SKOV3/TAX300和SKOV3/TAX30。 2.2 耐药细胞的生物特性 2.2.1 耐药指数
MTT实验结果显示,耐药细胞及其敏感细胞的IC50值及耐药指数,可见小剂量浓度递增诱导的耐药细胞SKOV3/TAX30耐药性较强,见表 2。
![]() |
在无药物作用时,SKOV3敏感细胞较两种耐药细胞系的克隆形成能力强,见图 1A的d组 ,SKOV3敏感细胞的克隆形成数为(934±16.37),SKOV3/TAX300的克隆形成数为(440±13.75),SKOV3/TAX30的克隆形成数为(579±9.50)。与敏感细胞SKOV3相比,两种耐药细胞克隆形成数少,差异有统计学意义(P均=0.000),见图 1B。
![]() |
| **: P<0.01,*: P<0.05,compared with SKOV3 cells a: TAX 500nM group; b: TAX 50nM group; c: TAX 5nM group; d: TAX 0nM group 图 1 SKOV3,SKOV3/TAX300和SKOV3/TAX30细胞的平板克隆形成结果Figure 1 Colony formation assay of SKOV3,SKOV3/TAX300 and SKOV3/TAX30 cells |
而在相同浓度紫杉醇作用下,耐药细胞形成的克隆明显多于敏感细胞。在紫杉醇浓度为5 nM时,SKOV3/TAX30可形成(1 206±9.50)个克隆,SKOV3/TAX300可形成(870±32.30)个克隆,而SKOV3形成的克隆数仅(202±6.08),差异有统计学意义(P均=0.000);当紫杉醇浓度进一步升高为50 nM和500 nM时,SKOV3/TAX30和SKOV3/TAX300形成的克隆数仍明显高于敏感细胞SKOV3。紫杉醇浓度为50 nM时,SKOV3细胞与SKOV3/TAX300细胞形成的克隆数相比,差异有统计学意义(P=0.013),SKOV3细胞与SKOV3/TAX30细胞形成的克隆数相比,差异也有统计学意义(P=0.000); 紫杉醇浓度为500 nmol/L时,SKOV3细胞与SKOV3/TAX300和SKOV3/TAX30细胞形成的克隆数相比,差异有统计学意义(P=0.009、0.0001),见图 1B。 2.2.3 生长曲线倍增时间的差异
SKOV3敏感细胞和两种耐药细胞系在相同条件下培养7天,细胞增殖产生一定的差异。耐药细胞的生长较敏感细胞减慢,生长曲线的斜率减小,见图 2。同时,根据生长曲线计算出SKOV3/TAX300和SKOV3/TAX30细胞的倍增时间分别为28.90 h、24.0 h,与敏感细胞的倍增时间20.84 h相比也有所延长。
![]() |
| 图 2 SKOV3,SKOV3/TAX300和SKOV3/TAX30细胞的生长曲线Figure 2 Growth curves of SKOV3,SKOV3/TAX300 and SKOV3/TAX30 cells |
MDR1、BCL2L1、LRP、PRKCA mRNA在SKOV3、SKOV3/TAX300和SKOV3/TAX30细胞中的相对表达丰度见图 3A、3B。两种耐药细胞中,MDR1的表达明显增高,提示SKOV3/TAX300、SKOV3 /TAX3 0对紫杉醇的耐药与MDR1高表达有关。SKOV3/TAX300细胞中PRKCA、LRP的表达均高于SKOV3细胞,差异有统计学意义(P=0.016,P=0.005),BCL2L1的表达与敏感细胞比较,差异无统计学意义(P=0.815)。而SKOV3/TAX30细胞的PRKCA、LRP的表达与敏感细胞比较差异无统计学意义(P=0 .1 5 4,P= 0.206) 。BCL2L1的表达低于敏感细胞(P=0.001),见图 3B。以上数据表明不同诱导方式导致耐药细胞发生不同生物学变化,可能存在不同的耐药机制。
![]() |
| **: P<0.01,*: P<0.05,compared with SKOV3 cells 图 3 耐药相关基因MDR1、BCL2L1、LRP、PRKCA mRNA在SKOV3、SKOV3/TAX300和SKOV3/TAX30细胞中的相对表达丰度 Figure 3 The relative expression abundance of MDR1, BCL2L1,LRP and PRKCA mRNA in SKOV3,SKOV3/TAX300 and SKOV3/TAX30 cells |
耐药细胞SKOV3/TAX30分别冻存在含有0、10、30 nM紫杉醇的冻存液中,于冻存后1、3、6月复苏,检测IC50,见表 3。1、3月后检测结果提示,在3种药物浓度条件下的细胞IC50没有明显区别,但冻存6月后,无药冻存组的耐药细胞与两种加药冻存组的细胞比较,其IC50明显下降,差异有统计学意义(P<0.01)。同一个药物浓度条件下,无药冻存组的耐药细胞在冻存6月时,出现耐药性下降,而两种加药冻存组细胞在6月的冻存过程中,细胞IC50虽然出现轻度下降,但差异无统计学意义。
![]() |
本实验结果提示:增加给药剂量、适当延长无药间歇期,可能延缓细胞的耐药性。由于大剂量冲击诱导与临床治疗模式相似,临床上体内耐药指数≥2倍即足以导致化疗失败[5],因此大剂量冲击诱导产生的耐药细胞虽然耐药指数较低,也是模拟临床耐药的良好模型。3.2 耐药细胞的特性
本研究的结果表明 :在无药物作用时,SKOV3细胞的集落形成能力强于两种耐药细胞SKOV3/TAX300和SKOV3/TAX30,但在不同浓度紫杉醇药物条件下,耐药性最强的SKOV3/TAX30集落形成能力也最强,而敏感细胞SKOV3的集落形成能力最弱,此结果与MTT法检测的耐药性一致。
紫杉醇的作用机制是促进微管蛋白二聚体装配成微管,抑制纺锤体形成,将细胞阻断于G2/M期,细胞的有丝分裂异常或停止,使多核细胞的形成增多[6]。诱导的过程中耐药细胞膨胀、形态不规则、细胞体积的增大可能与细胞群体中多核细胞的增多有关。
本研究的生长曲线实验中,SKOV3/TAX300和SKOV3/TAX30的倍增时间分别为28.9、24.0 h,与敏感细胞SKOV3的倍增时间20.84 h相比有明显延长,显示耐紫杉醇的卵巢癌细胞生长速度减慢。细胞周期的阻滞,除导致一些细胞周期特异性药物失效外,肿瘤细胞处于相对静止状态,易对化疗药物产生耐受。3.3 耐药相关基因的检测
卵巢癌紫杉醇耐药机制的研究中,多药耐药(multidrug resistance,MDR)一直是热点。多药耐药是指对一种药物具有耐药性的同时,也对其他结构和作用机制完全不同的化疗药物产生交叉耐受的一种现象。多药耐药的产生是一个多因素的过程,主要包括:(1)细胞内有效药物浓度的降低;(2)细胞内药物活性的改变;(3)凋亡的抑制;(4)肿瘤细胞微环境改变化疗敏感度。
P-gp是多药耐药基因MDR1编码的相对分子质量为17 kD的一种跨膜糖蛋白,其功能是使细胞内药物浓度降低,药物的作用减弱或丧失,细胞由此获得耐药性。与大多数其他化疗药物的多药耐药机制相似,紫杉醇作为P-gp的作用底物之一,其耐药机制与MDR1基因扩增导致的P-gP高表达密切相关[7, 8]。肺耐药相关蛋白LRP是在多药耐药的肺癌细胞株中发现的与MDR相关的非糖蛋白,相对分子质量为110 kD,能阻止药物通过核孔进入细胞核,避免其作用于核内靶点,药物运送到胞质的囊泡中,再通过胞吐作用将药物排出体外,从而发生紫杉类药物耐药[9, 10]。
凋亡抑制基因也参于紫杉醇耐药。BCL2L1基因,全称为BCL-2样1基因(BCL-2-like 1),编码蛋白属于BCL-2蛋白家族,BCL-2蛋白家族通过抑制肿瘤细胞凋亡,导致耐药性[11, 12]。PRKCA基因为蛋白激酶Cα(protein kinase C alpha),也被称为PKCA、PRKACA、KPCA、AAG6。细胞过度增殖和抗细胞凋亡机制障碍都可导致肿瘤进展和耐药现象发生[13]。另外PKC的作用是使底物蛋白磷酸化而活化,p-gp是PKC的作用底物,当其表达增加或活性增强时,可使大量的P-gp磷酸化而活化,从而产生耐药性。
本研究结果提示。SKOV3/TAX300细胞P RK CA、L RP的表达均略高于敏感细胞。但SKOV3/TAX30细胞的PRKCA、LRP的表达与敏感细胞比较差异无统计学意义。BCL2L1在SKOV3/TAX3 0细胞的表达低于敏感细胞,但SKOV3/TAX300细胞中BCL2L1的表达略高于敏感细胞,结果提示不同方式诱导的耐药细胞,可能存在不同的耐药机制。3.4 耐药细胞的保存
研究表明耐药表型在无药培养液中具有不稳定性[14, 15],而且随着时间的推移,耐药水平也逐渐下降,有的甚至恢复到亲代细胞的敏感度。智星等[16]对耐阿霉素的人肝癌细胞采用持续加药培养的方法保种传代,可提供研究所用的具有相对稳定性的耐药细胞株。本实验在实验初期同样遇到了复苏长期保存的耐药细胞,发现其耐药特性丢失的问题,为了摸索化疗耐药细胞长期保存的条件,我们改变细胞冻存条件,将耐药细胞SKOV3/TAX30冻存在含一定药物浓度的冻存液中,冻存液中药物浓度根据细胞诱导时的药物浓度确定为10和30 nmol/L。实验结果提示,耐药细胞冻存在含一定浓度化疗药物的条件下,较无药冻存更能保存耐药的稳定性,从而有利于提供稳定的体外模型。
| [1] | Siegel R, Naishadham D, Jemal A. Cancer statistics, 2012[J]. CA Cancer J Clin, 2012, 62(1): 10-29. |
| [2] | Markman M, Markman J, Webster K, et al. Duration of response to second-line, platinum-based chemotherapy for ovarian cancer:implications for patient management and clinical trial design[J]. J Clin Oncol, 2004, 22(15): 3120-5. |
| [3] | Li HX, Zhang WJ, Zhang SM. Establishment of Taxol-resistance ovarian carcinoma cell line SKOV3/TAX and study of its multidrug resistant mechanism [J]. Shan Dong Yi Yao, 2008, 48(6):26-8.[李红霞, 张文晶, 张素梅. 卵巢癌紫杉醇耐药细胞株的建立及其耐药机制探讨[J]. 山东医药, 2008, 48(6): 26-8.] |
| [4] | Zhang J, Zhao J, Zhang W, et al. Establishment of paclitaxelresistant cell line and the underlying mechanism on drug resistance[J]. Int J Gynecol Cancer, 2012, 22(9): 1450-6. |
| [5] | Desoize B, Jardillier J. Multicellular resistance: a paradigm for clinical resistance[J]. Crit Rev Oncol Hematol, 2000, 36(2-3): 193-207. |
| [6] | Liang Y, Meleady P, Cleary I, et al. Selection with melphalan or paclitaxel (Taxol) yields variants with different patterns of multidrug resistance, integrin expression and in vitro invasiveness[J]. Eur J Cancer, 2001, 37(8): 1041-52. |
| [7] | Duan Z, Brakora KA, Seiden MV. Inhibition of ABCB1 (MDR1) and ABCB4 (MDR3) expression by small interfering RNA and reversal of paclitaxel resistance in human ovarian cancer cells[J].Mol Cancer Ther, 2004, 3(7): 833-8. |
| [8] | Lee JP, Hahn HS, Hwang SJ, et al. Selective cyclooxygenase inhibitors increase paclitaxel sensitivity in taxane-resistant ovarian cancer by suppressing P-glycoprotein expression[J]. J Gynecol Oncol, 2013, 24(3): 273-9. |
| [9] | Scheffer GL, Schroeijers AB, Izquierdo MA, et al. Lung resistance-related protein/major vault protein and vaults in multidrug-resistant cancer[J]. Curr Opin Oncol, 2000, 12(6): 550-56. |
| [10] | Kerr EH, Frederick PJ, Egger ME, et al. Lung resistance-related protein (LRP) expression in malignant ascitic cells as a prognostic marker for advanced ovarian serous carcinoma[J]. Ann Surg Oncol, 2013, 20(9): 3059-65. |
| [11] | Korbakis D, Scorilas A. Quantitative expression analysis of the apoptosis-related genes BCL2, BAX and BCL2L12 in gastric adenocarcinoma cells following treatment with the anticancer drugs cisplatin, etoposide and taxol[J]. Tumour Biol, 2012, 33(3): 865-75. |
| [12] | Williams J, Lucas PC, Griffith KA, et al. Expression of Bcl-xL in ovarian carcinoma is associated with chemoresistance and recurrent disease[J]. Gynecol Oncol, 2005, 96(2): 287-95. |
| [13] | Zhao LJ, Xu H, Qu JW, et al. Modulation of drug resistance in ovarian cancer cells by inhibition of protein kinase C-alpha (PKC-α) with small interference RNA (siRNA) agents[J]. Asian Pac J Cancer Prev, 2012, 13(8): 3631-6. |
| [14] | Keizer HG, Schuurhuis GJ, Broxterman HJ, et al. Correlation of multidrug resistance with decreased drug accumulation, altered subcellular drug distribution, and increased P-glycoprotein expression in cultured SW-1573 human lung tumor cells[J]. Cancer Res, 1989, 49(11): 2988-93. |
| [15] | Twentyman PR, Fox NE, Wright KA, et al. Derivation and preliminary characterisation of adriamycin resistant lines of human lung cancer cells[J]. Br J Cancer, 1986, 53(4): 529-37. |
| [16] | Zhi X, Yan LN, Lin P, et al. Establishment of AdriamycinResistance Cell Substrain SMMC-7721 / Adriamycin of Human Hepatocellular Carcinoma and Research of Its Characteristics[J].Zhong Guo Pu Wai Ji Chu Yu Lin Chuang Za Zhi, 2004, 11(3): 219-23. [智星, 严律南, 林萍, 等. 人肝细胞癌耐阿霉素细胞亚株SMMC-7721/ADM的诱导及其特征研究[J]. 中国普外基础与临床杂志, 2004, 11(3): 219-23.] |
2015, Vol. 42